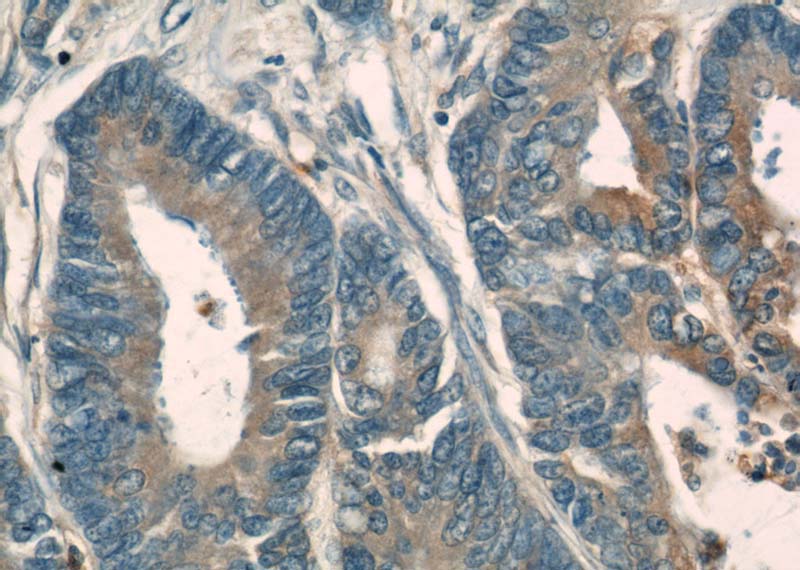
Immunohistochemical of paraffin-embedded human colon cancer using Catalog No:113859(PKM antibody) at dilution of 1:50 (under 40x lens)

-
Product Name
PKM antibody
- Documents
-
Description
PKM Rabbit Polyclonal antibody. Positive IHC detected in human colon cancer tissue. Positive WB detected in multi-cells/tissue, HEK-293 cells, HeLa cells, HepG2 cells, Jurkat cells, MCF7 cells, NIH/3T3 cells, Raji cells, SH-SY5Y cells, SKOV-3 cells. Observed molecular weight by Western-blot: 58 kDa
-
Tested applications
ELISA, IHC, WB
-
Species reactivity
Human, Mouse; other species not tested.
-
Alternative names
CTHBP antibody; OIP 3 antibody; OIP3 antibody; Opa interacting protein 3 antibody; p58 antibody; PK2 antibody; PK3 antibody; PKM antibody; PKM1 antibody; PKM2 antibody; PKM2 pyruvate kinase antibody; muscle antibody; Pyruvate kinase 2/3 antibody; Pyruvate kinase isozymes M1/M2 antibody; Pyruvate kinase muscle isozyme antibody; TCB antibody; THBP1 antibody; Tumor M2 PK antibody
-
Isotype
Rabbit IgG
-
Preparation
This antibody was obtained by immunization of PKM recombinant protein (Accession Number: NM_002654). Purification method: Antigen affinity purified.
-
Clonality
Polyclonal
-
Formulation
PBS with 0.1% sodium azide and 50% glycerol pH 7.3.
-
Storage instructions
Store at -20℃. DO NOT ALIQUOT
-
Applications
Recommended Dilution:
WB: 1:500-1:5000
IHC: 1:20-1:200
-
Validations

WB result of Catalog No:113859 (PKM antibody) with various lysates.

Immunohistochemical of paraffin-embedded human colon cancer using Catalog No:113859(PKM antibody) at dilution of 1:50 (under 10x lens)
Immunohistochemical of paraffin-embedded human colon cancer using Catalog No:113859(PKM antibody) at dilution of 1:50 (under 40x lens)
-
Background
PKM, also named as OIP3, PK2, PK3, PK-M1/2, p58, THBP1, CTHBP and Tumor M2-PK, belongs to the pyruvate kinase family. It is glycolytic enzyme that catalyzes the transfer of a phosphoryl group from phosphoenolpyruvate (PEP) to ADP, generating ATP. It stimulates POU5F1-mediated transcriptional activation. PKM plays a general role in caspase independent cell death of tumor cells. The activity of the M2 isoform (but not the M1 isoform) can be inhibited by tyrosine kinase signalling in tumourcells.The primary pyruvate kinase isoform before tumour development is PK-M1; however, the primary isoform from four independent tumours is PK-M2.(PMID:18337823). PKM, Pyruvate kinase isozymes M1/M2, has 2 isoforms . This antibody can recognize both PK-M1 and PK-M2.
-
References
- Yu Y, Pan X, Ding Y. An iTRAQ based quantitative proteomic strategy to explore novel secreted proteins in metastatic hepatocellular carcinoma cell lines. The Analyst. 138(16):4505-11. 2013.
Related Products / Services
Please note: All products are "FOR RESEARCH USE ONLY AND ARE NOT INTENDED FOR DIAGNOSTIC OR THERAPEUTIC USE"
